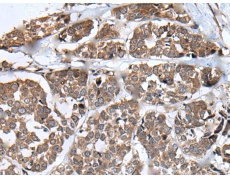
一抗

中文名稱: 兔抗NSD2多克隆抗體
英文名稱: Anti-NSD2 rabbit polyclonal antibody
別 名: nuclear receptor binding SET domain protein 2; WHS
相關(guān)類別: 一抗
儲 存:冷凍(-20℃)
宿 主: Rabbit
抗 原: NSD2
反應種屬: Human
標 記 物: Unconjugate
克隆類型: rabbit polyclonal
技術(shù)規(guī)格
|
Background: |
This gene encodes a protein that contains four domains present in other developmental proteins: a PWWP domain, an HMG box, a SET domain, and a PHD-type zinc finger. It is expressed ubiquitously in early development. Wolf-Hirschhorn syndrome (WHS) is a malformation syndrome associated with a hemizygous deletion of the distal short arm of chromosome 4. This gene maps to the 165 kb WHS critical region and has also been involved in the chromosomal translocation t(4;14)(p16.3;q32.3) in multiple myelomas. Alternative splicing of this gene results in multiple transcript variants encoding different isoforms. Some transcript variants are nonsense-mediated mRNA (NMD) decay candidates, hence not represented as reference sequences. [provided by RefSeq, Jul 2008] |
|
Applications: |
ELISA, IHC |
|
Name of antibody: |
NSD2 |
|
Immunogen: |
Synthetic peptide of human NSD2 |
|
Full name: |
nuclear receptor binding SET domain protein 2 |
|
Synonyms: |
WHS; TRX5; KMT3F; KMT3G; MMSET; WHSC1; REIIBP |
|
SwissProt: |
O96028 |
|
IHC positive control: |
Human colorectal cancer |
|
IHC Recommend dilution: |
25-100 |

 購物車
購物車 幫助
幫助
 021-54845833/15800441009
021-54845833/15800441009